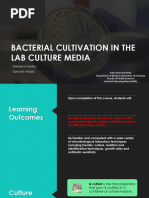

0% found this document useful (0 votes)
54 views9 pagesNutrients in The Liquid: Culture Media Liquid Media Selective Media
Culture media are used to isolate and identify microorganisms. There are three main types - enrichment media which encourages growth of specific microbes, selective media which inhibits some microbes, and differential media which distinguishes microbes based on biochemical reactions. Different media are used depending on the specimen type, such as blood agar and chocolate agar for sputum and anaerobic blood agar and thioglycollate broth for tissues.
Uploaded by
Precious Mae Cuerquis BarbosaCopyright
© © All Rights Reserved
We take content rights seriously. If you suspect this is your content, claim it here.
Available Formats
Download as DOCX, PDF, TXT or read online on Scribd
0% found this document useful (0 votes)
54 views9 pagesNutrients in The Liquid: Culture Media Liquid Media Selective Media
Culture media are used to isolate and identify microorganisms. There are three main types - enrichment media which encourages growth of specific microbes, selective media which inhibits some microbes, and differential media which distinguishes microbes based on biochemical reactions. Different media are used depending on the specimen type, such as blood agar and chocolate agar for sputum and anaerobic blood agar and thioglycollate broth for tissues.
Uploaded by
Precious Mae Cuerquis BarbosaCopyright
© © All Rights Reserved
We take content rights seriously. If you suspect this is your content, claim it here.
Available Formats
Download as DOCX, PDF, TXT or read online on Scribd
/ 9